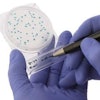

Hardy Diagnostics
Santa Maria, California 93455
Company Overview
1430 W. McCoy Lane
Santa Maria, California 93455
United States
Phone:+1.805.346.2766
Products
Editorial & News
Fill out the form below to request more information about Hardy Diagnostics